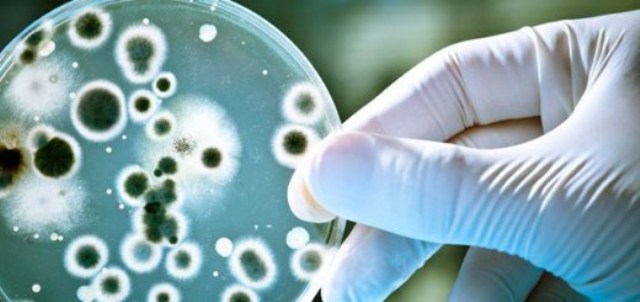

Ritorna il “terrore di Robespierre…” a farne le spese poliziotti e cittadini onesti che denunciano situazioni di degrado, “la brava gente esasperata è sempre più intimorita dai provvedimenti dello Stato”

dr Fabrizio Locurcio, Responsabile dello Sportello del Poliziotto, Segreteria Provinciale CONSAP di Roma
Purtroppo è un dato di fatto che il cittadino è sempre più “minacciato” da sanzioni pecuniarie, provvedimenti disciplinari al lavoro, dalla riduzione degli stipendi, dai conguagli impazziti, dal fisco, dai vaccini non somministrati, dalla malasanità, invalidi costretti a lavorare e falsi invalidi campioni di Free Climbing ed ora Equitalia che, da azienda privata, diventa Agenzia delle Entrate, al fine di poter avviare di imperio, le procedure esecutive di riscossione delle tasse. E nessuno parla delle decine di migliaia di dipendenti della società che da un giorno all’altro li ha trasformati in dipendenti pubblici in forza al Ministero dell’Economia, senza concorso mentre i nostri figli laureati, per 600 euro debbono accettare posti nei call center o al Mc Donald…e qualcuno li ha definiti perfino fannulloni figli di mamma e di papà!
Lo sfogo dei cittadini sui social media non basta a placare la collera nei confronti di uno Stato patrigno che è sempre più contro i cittadini onesti, la vessazione contro le Forze dell’Ordine, la totale assenza di regole per alcuni che impone una riflessione, il delinquente è sempre più garantito e vive e continua a vivere senza regole, l’uomo onesto deve combattere una guerra quotidiana con assassini che uccidono per un diverbio stradale e tornano presto a guidare sulle stesse strade e con la stessa patente grazie all’indulgenza della legge che applica l’istituto della riabilitazione e ladri che girano indisturbati, immigrati senza controllo che continuano a privare i cittadini italiani di molti diritti fondamentali, casa, vita dignitosa e sicurezza che ormai è una chimera in questo Paese!
Una magistratura che indaga il poliziotto e il cittadino che si difende dal criminale, permessi premio a pluriomicida con i quali diventano latitanti per commettere altri reati, Istituzioni intoccabili che non possono nemmeno essere nominate, pena la sospensione dal lavoro e dalla paga, come non avveniva nei tempi del tanto esecrato periodo fascista, cittadini che per evitare sfratti o poter mangiare un tozzo di pane debbono andare a raccogliere nei rifiuti dei mercati gli scarti alimentari oppure debbono fare appelli in Tv, sperando che qualche misericordioso benestante si preoccupi del loro caso….ecc.ecc. ma lo Stato quello che dovrebbe preservare, garantire, sostenere ed evitare tutto questo dov’è? Quello stato democratico, di diritto, di equità sociale, contro le disuguaglianze, favorevole all‘esercizio dei propri diritti di libertà di espressione e di pensiero, contro gli abusi e le prepotenze del potere dove è finito?
Questo clima di impotenza generale è determina o dal timore di perdere il lavoro e quelle poche certezze conquistate, mentre chi non lo ha teme di non poterlo avere mai. “Arbeit macht frei”!
Il lavoro rende liberi!
dr Fabrizio Locurcio
Responsabile Sportello del Poliziotto
Segreteria Provinciale di Roma – CONSAP